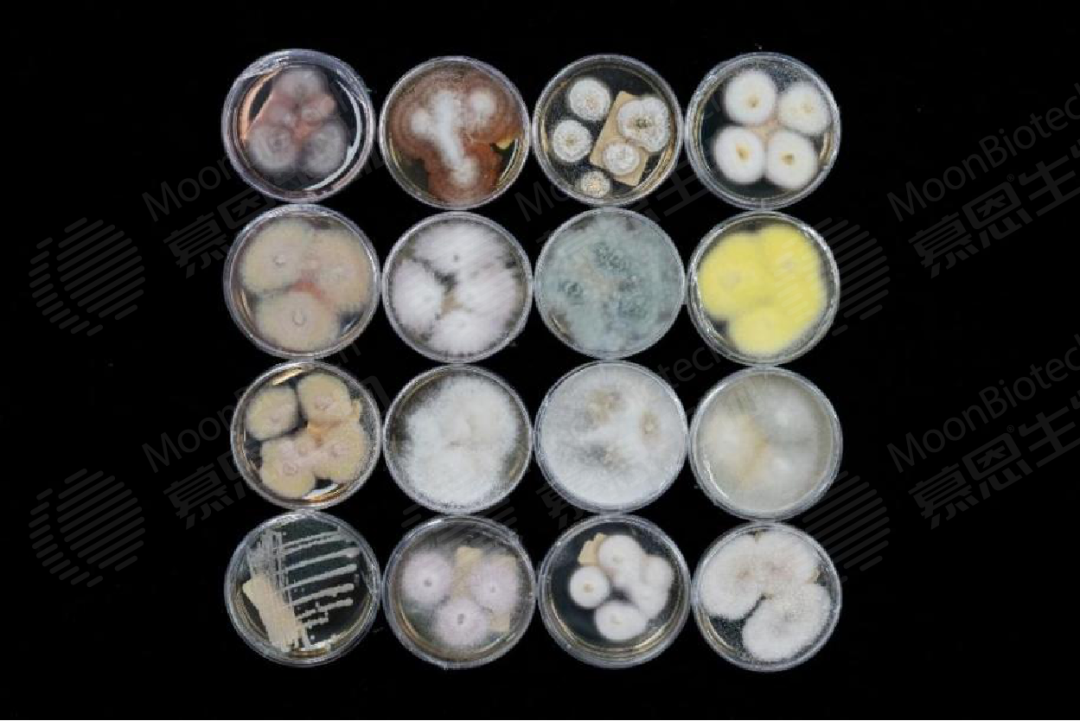

突破
No.1 隐冠半导体第100台压电减振台顺利交付
10月16日,隐冠半导体自主研发生产的第100台XZ压电(定位)减振台成功发运交付。产品实现了多项从零到一的技术突破,创新性地采用压电技术实现悬挂结构下主动减振功能,成功地将定位与减振功能融合于一体,打造出高集成度的XZ定位减振台,攻克了领域内长期存在的技术瓶颈,目前已成功应用于国家大科学装置。

No.2 大特气体在津开设全资子公司
大特气体日前在天津经开区成立全资子公司大特(天津)气体有限公司,并计划在经开区南港工业区建设特气项目。该项目总投资额1.05亿元,占地约2万平方米,依托南港工业区的区位与资源优势,将建设电子特气、实验室特气及医用混合气生产线,重点满足京津冀地区特种气体市场的需求。项目预计于2026年开工,2027年建成并投产。
No.3 浙江化讯智慧工厂正式通线
10月28日,浙江化讯半导体材料有限公司智慧工厂正式通线,项目总投资超2亿元,投产后可实现年产泛半导体先进封装材料225吨,年产值超3亿元。该工厂位于嘉善经济技术开发区,占地面积约35亩,建筑面积超2.4万平方米,具备先进电子材料大规模生产的洁净厂房和MES生产管理系统。该智慧工厂作为化讯半导体材料有限公司国内唯一的生产基地,将负责公司核心产品全流程规模化生产。
No.4 蓝动精密燕罗制造中心项目开工
10月30日,蓝动精密燕罗制造中心举行开工奠基仪式,燕罗制造中心将建设百/千级无尘生产车间、自动化配销中心、高精密研发及测试平台。
No.5 欧莱新材新工厂G10.5世代线ITO靶材出货
近期,欧莱新材新工厂为客户供应的G10.5世代线ITO靶材成功出货。G10.5世代线是目前全球液晶面板制造的最高世代生产线,主要生产60英寸以上的大尺寸液晶面板。在G10.5世代线中,ITO靶材主要用于制备透明导电薄膜,是显示面板制造中的关键材料。

No.6 慕恩生物再增万株珍稀菌种
慕恩生物日前宣布,第三季度在系统性微生物资源勘探中再次取得重要进展,圆满完成对热带雨林(海南)、亚热带常绿阔叶林(粤北)与红壤丘陵森林(赣南)三大典型生态区的深度勘探考察,成功从首批样本中分离、鉴定和保藏超过10000株真菌菌株。
No.7 航瑞动力获批组建“安徽省产业创新中心”
近日,安徽省发展改革委对2025年度省产业创新中心“揭榜挂帅”的组建及验收评审结果进行公示,航瑞动力“安徽省低空飞行动力系统产业创新中心”获批组建。
No.8 邦盛科技牵头参与的行业标准正式发布
近日,工业和信息化部发布公告,由邦盛科技牵头制定的《智能决策系统和工具技术要求》《智能风控平台指标要求和评估方法》2项行业标准及参与制定的《大规模预训练模型技术和应用评估方法第4部分:可信要求》1项行业标准正式获批,以上3项标准将于2025年12月1日起全面实施。
合作
No.9 新迪数字参加工业知识联盟成立仪式
10月15日,新迪数字受邀参加由广东省工业和信息化厅指导、深圳市龙岗区人民政府主办,华为技术有限公司、深圳市高新企业数字化学会联合承办的工业知识联盟(OpenKAG)成立仪式,并成为联盟初始成员单位。该联盟汇聚政、产、学、研、用多方力量,构建国家级工业知识创新平台,以工业知识图谱为核心,推动工业知识协同创新从分散探索迈入标准化、规模化新阶段。

No.10 先通医药获选国家心血管病专家委员会影像专委会首届委员单位
近日,国家心血管病专家委员会心血管影像专业委员会正式成立。该委员会由胡盛寿院士等专家发起、王振常院士担任首届主任委员,汇聚全国心血管影像领域百名顶尖专家。先通医药作为国内创新放射性药物领跑企业,荣誉入选影像专委会首届委员单位。

上榜
No.11 先艺电子荣获“中国好技术”A类奖
近日,由中国生产力促进中心协会联合全国各级生产力促进中心、协会以及相关机构和企业共同发起和开展的2024年度“中国好技术”项目库入选名单公示。先艺电子自主研发的“高可靠性封装金属互连材料”入选“中国好技术”项目库(A类)并荣获“中国好技术”称号。
No.12 深开鸿荣获中国计算机学会“技术发明一等奖”
10月24日,由深开鸿联合北京大学、国铁吉讯公司共同完成的“面向移动物联网的高性能互联关键技术及应用”在中国计算机学会(CCF)主办的2025中国计算机大会颁奖典礼上荣获“技术发明一等奖”。

No.13 科德数控荣获2025年度“机械工业科学技术奖”两项一等奖
日前由中国机械工业联合会、中国机械工程学会发布2025年度“机械工业科学技术奖”奖励项目名单,科德数控荣获两项一等奖,主持完成的“高性能五轴数控系统及其重大工程应用”荣获机械工业科技进步一等奖,参与完成的“硬质合金刀具高性能制造及服役智能监测与诊断技术”荣获机械工业技术发明一等奖。
